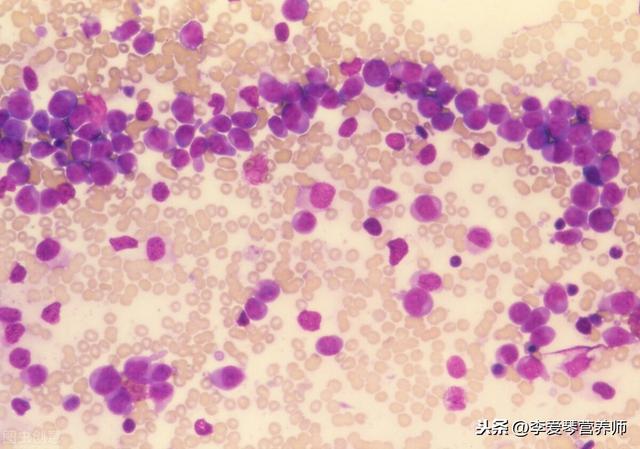

Existe-t-il un lien entre les cheveux gris et le cancer ?
Existe-t-il un lien entre les cheveux gris et le cancer ? 
Quel est le lien entre les cheveux gris et le cancer ?
Quoi qu'il en soit, c'est moi qui y ai cru en premier. En raison de ma blancheur ancestrale d'adolescente, il semble que le cancer soit encore loin de moi.
Je plaisante.
Les principales causes du grisonnement des cheveux sont la génétique, les facteurs psychiatriques et les défauts de la tyrosinase. Les facteurs génétiques représentent une grande partie de ces causes. Les défauts de la tyrosinase, le manque d'oligo-éléments, tels que l'insuffisance de zinc, de cuivre et de fer dans l'organisme ou des niveaux élevés de plomb dans le sang, peuvent être à l'origine des cheveux gris. En outre, les facteurs mentaux sur l'impact des cheveux gris sont également cruciaux, lorsqu'une personne est sous la pression de sa limite la plus élevée, elle ne peut pas être chargée, ce qui accélère le passage des cheveux noirs aux cheveux blancs. Le dicton populaire selon lequel "une nuit d'inquiétude rend la tête blanche" n'est pas exagéré, et le Dr Ho a rencontré de nombreux cas de ce type. Les cheveux gris n'ont donc rien à voir avec la lutte contre le cancer.
Aujourd'hui, les cheveux blancs sont couramment acquis, trop de pression, souvent des heures supplémentaires, le repos n'est pas bon, le régime alimentaire n'est pas régulier, ces personnes peuvent utiliser la saponine de ginseng rh2 (capsule Jinxing) pour améliorer la constitution, améliorer la capacité de l'organisme à résister aux maladies. Le ginsénoside rh2 libère des facteurs immunitaires.
Selon l'étude actuelle sur les cheveux gris et l'anticancéreux, il n'y a aucune corrélation, les cheveux gris désignent généralement les cheveux gris acquis, qui sont divisés en cheveux gris séniles et en cheveux gris prématurés, les cheveux gris séniles sont souvent un phénomène physiologique qui apparaît avec l'âge. Les cheveux gris au début de la vie, également connus sous le nom de cheveux blancs juvéniles, se produisent chez les enfants, les adolescents ou les personnes d'âge moyen (<40 ans) d'une maladie acquise des cheveux partiellement ou complètement blancs, les cheveux blancs affecteront la beauté du patient, mais l'anticancéreux des cheveux blancs est un peu tiré par les cheveux.
Il existe de nombreuses causes de cheveux gris prématurés, que l'on peut généralement diviser en deux catégories : héréditaire et acquise. Les cheveux blancs prématurés héréditaires ont généralement des antécédents familiaux de morbidité, se manifestant par une transmission autosomique dominante, certains patients étant également accompagnés d'un syndrome de vieillissement prématuré.
Les cheveux gris prématurés acquis sont liés à divers facteurs, tels que les facteurs mentaux, un mauvais état nutritionnel, les troubles endocriniens, la réduction des cellules souches pigmentaires et le stress. Les principaux facteurs d'apparition de cheveux gris précoces sont : la réduction ou la disparition du nombre de mélanocytes dans le follicule pileux ; la présence d'inhibiteurs de la tyrosinase dans l'organisme ; la réduction ou la disparition de la production de tyrosine ; l'altération de la synthèse de la mélanine ; l'altération de la migration de la mélanine des mélanocytes de la mère du cheveu vers le cortex du cheveu ; et la destruction directe du cheveu par des substances physiques ou chimiques externes.
Ces dernières années, on a constaté que les personnes ayant une faible expression des gènes Mitf et Slc7a11 sont plus susceptibles de développer des cheveux gris précoces, car une expression réduite de ces deux gènes entraîne une augmentation de la sensibilité des mélanocytes aux stimuli oxydatifs, ce qui conduit à l'apoptose des mélanocytes, qui ne sont pas en mesure de produire suffisamment de mélanine pour provoquer des cheveux gris. Aucune corrélation n'a été trouvée entre ces deux gènes et le type de tumeur maligne.
Après l'apparition des cheveux blancs, nous devons le traiter différemment, si les pères et les grands-pères sont des cheveux blancs précoces, que vous êtes des cheveux blancs héréditaires, le niveau actuel de la science médicale est encore très difficile à traiter les cheveux blancs du niveau génétique, mais vous pouvez vous dire haut et fort : je suis pro-vie n'est pas de charger une facture de téléphone pour envoyer le 😄. Si le travail est trop fatigué, trop de pression, manger le porc chien riz sec bovins et chevaux travail, arrêter et se reposer, rester dans la montagne verte n'a pas peur de pas de bois de chauffage.
Merci pour les questions-réponses ! Quel est le lien entre les cheveux gris et le cancer ? Personnellement, je ne pense pas qu'il y ait de corrélation entre les deux. Un membre de ma famille est atteint d'un carcinome épidermoïde et ses cheveux ne sont pas gris, une petite perte de cheveux, les cheveux gris n'ont rien à voir avec l'âge (beaucoup de personnes d'âge moyen dans le voisinage ont des cheveux essentiellement gris), ils devraient être liés aux habitudes de vie et aux micronutriments nécessaires à l'organisme.
Haha, vous exagérez vraiment en disant que les cheveux gris combattent le cancer !
Les cheveux blancs, pour les personnes modernes stressées par la vie, ne sont pas une chose nouvelle, beaucoup de personnes dans la trentaine ont des cheveux blancs, la médecine chinoise, les femmes ont commencé à pousser des cheveux blancs temps est de quarante-deux ans, progressivement commencé à avoir des cheveux blancs, bien sûr, cela est basé sur la condition physique de l'individu, certaines personnes plus tôt, certaines personnes plus tard quelques années, mais tôt ne peut pas être plus tôt que quarante-deux ans. Le fait d'avoir des cheveux blancs trop tôt montre que le corps a diverses raisons.

Les cheveux gris sont également une manifestation physiologique du vieillissement, car les cellules de mélanine diminuent progressivement avec l'âge, et les gens auront des cheveux gris lorsqu'ils atteindront la vieillesse. La mélanine est un pigment présent dans les plantes et les animaux, elle existe au milieu des cellules de la peau dans la couche basale de la peau, son rôle principal est de déterminer la couleur de la peau, lorsque le métabolisme des cellules de mélanine est inhibé ou que la production de mélanine diminue dans la peau, il y aura un certain nombre de maladies de la peau ou un blanchiment des cheveux.
Les principales raisons d'avoir des cheveux gris prématurés sont les suivantes :
1. les facteurs génétiques
Les facteurs génétiques se traduisent généralement par des cheveux moins gris, présents dès l'enfance.

2. les facteurs nutritionnels
La raison principale est que le régime alimentaire n'est pas raisonnable, ce qui entraîne un manque de certains nutriments pour la synthèse de la mélanine, comme le zinc, le zinc joue un double rôle dans la synthèse de la mélanine, le manque et l'excès peuvent entraîner une carence en mélanine. En outre, le manque de certains nutriments impliqués dans la synthèse des globules rouges peut également entraîner des cheveux gris. L'anémie en est la principale cause. Par exemple, la vitamine B2, l'acide folique, le fer, le cuivre, etc.
3. les facteurs mentaux
Trop de stress mental sur une longue période, l'insomnie, trop d'anxiété, la dépression, la tristesse, la tristesse, etc. peuvent conduire à l'apparition d'un grand nombre de cheveux gris, et nous avons vu le spectacle d'une tête blanche du jour au lendemain.
4. les facteurs de maladie
Outre les facteurs mentionnés ci-dessus, certaines maladies peuvent être à l'origine des cheveux gris, telles que l'anémie pernicieuse, le vitiligo, l'hyperthyroïdie et certaines maladies neurologiques.
Quel est le lien entre les cheveux gris et le cancer ?
Nous avons vu ci-dessus les causes des cheveux gris, et le cancer n'a pas de relation directe, même si une étude a trouvé une relation "mystérieuse" entre les cheveux gris et le cancer, elle est également prématurée, sans parler du fait que les cheveux gris peuvent être des allégations anticancéreuses qui n'ont pas été établies, du moins à l'heure actuelle, il n'y a pas de preuves concluantes pour les confirmer.
Du côté de ma mère, il y a une histoire génétique de cheveux gris, la plupart d'entre eux sont devenus gris dans la quarantaine et la cinquantaine, et lorsqu'ils ont atteint la cinquantaine, ils avaient déjà toute une chevelure grise, ce qui n'était pas du tout le cas de leurs pairs. Il y a aussi un collègue à côté de moi qui n'a que la quarantaine et qui a beaucoup de cheveux, et les gens l'appellent souvent en plaisantant "grand-père". Il y a eu un jour un reportage sur un médecin qui a lutté contre une épidémie et qui est devenu gris du jour au lendemain après plusieurs jours de combat continu. Il s'agit là de cas réels.
Existe-t-il un lien entre les cheveux gris et le cancer ?
L'allusion à la tête blanche d'une nuit est toujours transmise par Wu Zixu. On raconte que lorsque Wu Zixu fuyait la poursuite, il était si inquiet qu'il ne pouvait pas dormir et que, par conséquent, il a eu la tête blanche pendant une nuit, mais c'est précisément à cause des cheveux blancs qu'il n'a pas été reconnu et qu'il s'est donc échappé.
Lorsqu'il s'agit de cheveux blancs, la première impression de tout le monde est celle d'un vieil homme, généralement à l'âge de 60 ans ou plus, les cheveux blancs sont plus fréquents. Mais en fait, les cheveux blancs apparaissent à des âges très différents selon les personnes : certaines personnes n'ont que 20 ou 30 ans et ont déjà beaucoup de cheveux blancs, tandis que d'autres ont encore beaucoup de cheveux noirs à l'âge de 50 ou 60 ans.

Cela montre que ce n'est pas seulement l'âge qui détermine l'apparition précoce ou tardive des cheveux gris.
Nous savons que la couleur des cheveux varie d'un pays à l'autre, et la principale raison pour laquelle nos cheveux sont noirs est que la plupart des groupes de cellules responsables de la couleur des cheveux sont la mélanine. Avec l'âge, la pigmentation diminue ou disparaît et les cheveux gris apparaissent. Chez les jeunes, la substance responsable de la production de pigments est principalement la tyrosinase, qui ne peut être synthétisée que par elle-même, de sorte que si un déséquilibre de l'organisme entraîne une synthèse insuffisante, des cheveux gris prématurés peuvent également apparaître.
Les raisons spécifiques sont doubles :
Premièrement, les facteurs génétiques, c'est-à-dire les cheveux gris congénitaux, sont principalement dus à un manque de certains nutriments à la naissance, ou à l'absorption insuffisante de certains nutriments par l'organisme, ou à des troubles endocriniens congénitaux, la médecine chinoise parle d'insuffisance de dotation congénitale.
Le second est constitué de facteurs acquis, notamment la malnutrition, le stress chronique, la tension mentale, l'anxiété et la tristesse excessives, les traumatismes mentaux graves, le surmenage, les veillées prolongées, les maladies de dépérissement chroniques, les maladies endocriniennes, etc., ainsi que la teinture excessive des cheveux, les permanentes, l'exposition prolongée aux rayons ultraviolets, la pollution de l'environnement, etc. En médecine chinoise, les cheveux gris sont causés par la perte de qi et de sang, la chaleur du sang, l'exubérance du qi du foie et l'insuffisance de l'essence des reins.

Les cheveux gris sont-ils liés au cancer ?
La raison pour laquelle certaines personnes remettent cela en question est une étude qui a été réalisée. Cette étude a conclu que les personnes qui ont tendance à avoir les cheveux gris ont moins de risques de développer un cancer. En effet, les cellules souches productrices de mélanine sont retirées de l'organisme des personnes dont les cheveux gris poussent, ce qui constitue la clé de l'apparition d'un cancer. Cette étude ne manquera pas de faire sourciller lorsqu'elle sera publiée, mais est-elle vraiment vraie ?
Tout d'abord, l'étude aurait été démentie peu de temps après sa publication et a été supprimée depuis, mais comme elle a été publiée il y a longtemps, la nouvelle s'est répandue depuis. Mais le fait est que les cheveux gris ne sont pas causés par un manque de cellules souches, mais plutôt par un problème de production de mélanine. Les deux n'ont rien à voir l'un avec l'autre.
Il existe un certain lien avec l'hérédité, mais le plus souvent, ce sont les facteurs cancérigènes acquis, y compris les mauvaises habitudes de vie et l'exposition à long terme à des substances cancérigènes, qui sont les facteurs clés de l'apparition d'un cancer. Il n'y a pas de corrélation directe entre ce facteur et l'apparition de cheveux gris, et même les cheveux gris causés par des colorations fréquentes augmentent le risque de cancer. Il est donc manifestement impossible d'affirmer que les cheveux gris peuvent lutter contre le cancer.
Je suis le pharmacien Wang, qui s'efforce de diffuser des connaissances sur les maladies avec des mots simples et faciles à comprendre, et qui apporte sa petite contribution à une Chine en bonne santé. Si vous pensez que ma réponse vous est utile, n'hésitez pas à laisser un "j'aime" ! Si vous avez d'autres questions, n'hésitez pas à laisser un message, nous en discuterons ensemble !
Opinion : Il n'y a pas de relation directe, mais cela peut refléter l'état de vie auquel la personne est confrontée à un certain niveau ! Particulièrement pour les personnes non âgées, cela suggère que vous devez faire quelques ajustements dans votre vie !
J'ai été le témoin direct de trois femmes aux cheveux foncés devenant gris, toutes confrontées à ces changements de vie :
1. un choc mental important peut transformer les cheveux noirs en cheveux gris
Son fils unique, qui travaille dans un hôpital très réputé pour ses rhumatismes, entretient habituellement de bonnes relations avec moi, et il est très accueillant !
Âgé d'une trentaine d'années, il aidait un jour son beau-frère à nourrir les poissons lorsque ce dernier est malencontreusement tombé dans l'étang ! Pour autant que je m'en souvienne, ce copain était un véritable homme de l'eau !
Néanmoins, la tragédie a frappé et ils se sont tous les deux noyés !
En moins d'un mois, sa mère, aux cheveux noirs, est devenue grise ! Elle s'est trop chagrinée !
2. la vie est déprimante, l'intérieur se morfond, les cheveux noirs peuvent devenir blancs, à ce moment-là, les cheveux blancs ne sont pas seulement anticancéreux, ils peuvent aussi signifier que vous avez un risque de cancer !
Elle est décédée, à l'âge mûr, des suites de la maladie du foie de son mari ! Vivre seule avec quatre enfants peut s'avérer extrêmement lourd !
Pour le bien des enfants, elle n'a pas trouvé de nouvel objet, et chaque jour, la famille se préoccupe du travail ! Une tête aux cheveux noirs observée et surveillée, année après année, se transformant en cheveux blancs !
L'année dernière, elle a ressenti une douleur dans les seins et s'est rendue à Wuhan pour un examen de contrôle, au cours duquel on lui a diagnostiqué un cancer du sein ! Je lui ai recommandé un traitement actif ! Cela fait maintenant trois ans et tout va bien !
3. les cheveux noirs peuvent devenir gris même en cas de succession de résultats insatisfaisants
Il y a deux ans, sa belle-fille est décédée après avoir échoué dans son traitement contre le cancer du col de l'utérus ! Un soir, comme d'habitude, son mari est couché dans son lit et regarde la télévision. Son mari, bien qu'il ait toujours quelques problèmes mineurs, n'est pas en danger de mort.
Mais cette nuit-là, mon mari, dos au lit, s'est endormi en regardant la télévision, et puis il n'y a plus rien, plus aucun signe, et il est parti tranquillement !
Depuis, ses cheveux sont devenus tout gris !
résumés
Le grisonnement des cheveux est principalement lié à des facteurs psychosomatiques et les problèmes nutritionnels ne sont pas exclus ! Il peut répondre indirectement à l'état d'une personne ! L'anxiété et le stress excessifs affectent souvent l'immunité d'une personne, ce qui peut favoriser l'apparition de cancers et d'autres maladies !
La réponse à l'affirmation selon laquelle les cheveux gris combattent le cancer est non, il n'y a absolument rien de vrai dans cette affirmation !
Parce que l'essence du cancer est la mutation génétique, le cancer est une sorte de tumeur maligne, les cellules cancéreuses prolifèrent de manière maligne pour détruire la structure cellulaire normale, presser les organes normaux et, à un stade avancé, elles se métastasent partout pour former de nouveaux nids de cancer.
L'apparition d'un cancer est une combinaison de facteurs génétiques, d'habitudes de vie et de facteurs environnementaux. Les cellules normales du corps humain subissent des mutations génétiques au cours de leur prolifération, ce qui les transforme en cellules cancéreuses et finit par provoquer un cancer. Les cheveux gris, quelle qu'en soit la raison, sont dus à la réduction des particules de mélanine dans les cheveux et n'ont rien à voir avec le cancer.

Laissez-moi rire un peu.Quand les choses ne marchent pas, c'est le cancer qui s'en charge.Je suis sûre que le cancer est impliqué dans tout.
Mais nous sommes tous des gens civilisés, nous devons parler de preuves :Il n'y a pas vraiment eu d'étude établissant de manière concluante un lien entre les cheveux gris et le cancer.
Si les cheveux gris combattent le cancer, les médecins qui deviennent progressivement chauves devront s'inquiéter jusqu'à la mort !
L'expérience personnelle est la suivante :
Comme vous l'avez dit, l'augmentation des cheveux gris en cas de stress est scientifiquement prouvée et personnellement vécue !!!! En examinant le système immunitaire, le cercle des voies, la ligne d'articles ...... a frappé mon esprit fragile et gratté mon cuir chevelu, puis le résultat d'un raid d'un mois a été le suivantA peine le temps de passer + plus de cheveux gris
Pourquoi les cheveux gris augmentent-ils après le stress ?
Il n'est pas vraiment facile de l'expliquer, si ce n'est que jusqu'à présent, il entraîne une augmentation des cheveux gris, en plus de l'ingestion deInclusion de micronutriments tels que les carences en zinc et en cuivre, la génétique (que je considère personnellement comme le facteur le plus important) et les défauts de la tyrosine kinase, etc.Les deux peuvent conduire à une certaine augmentation des cheveux gris.
prévention et traitement
Nous ne savons donc pas s'il s'agit d'un anticancéreux, mais le stress est à l'origine de certaines maladies, comme les troubles endocriniens, etc. Le traitement ciblé est donc très utile, pour soulager le stress, pour que l'humeur soit bonne afin de garantir la santé physique et mentale de base.
Quoi qu'il en soit, chaque jour est un jour où l'on peut être heureux et un jour où l'on peut être ennuyé, en fonction de ce que l'on choisit de faire. ......
Je suis @FrontierPop, n'hésitez pas à suivre et à aimer les commentaires et à dire ce que vous pensez.
Perte de cheveux, chute de cheveux, cheveux gris. Tout cela est humain. Mauvaise humeur. Mauvais sommeil à long terme, mauvaise alimentation. Essence insuffisante. Avec le temps, provoque la chute des cheveux, chute des cheveux blancs.
On dit que les causes des cheveux gris sont le manque de force du foie, le stress, l'excès de considération, le mauvais fonctionnement des capillaires à l'extrémité des cheveux, ce qui entraîne une malnutrition des cheveux, etc. On dit que, bien que les cheveux gris n'aient rien à voir avec l'incidence du cancer, il semble que la proportion de personnes ayant des cheveux gris précoces souffrant d'un cancer soit inférieure à celle des personnes ayant des cheveux gris tardifs. Bien sûr, il n'y a pas de vérité scientifique ici, et je ne sais pas si quelqu'un a fait un échantillonnage. Mais certains des cheveux cancéreux que j'ai vus n'étaient vraiment pas très blancs. L'un de nos anciens directeurs départementaux, âgé d'une cinquantaine d'années, qui avait encore une chevelure noire bien fournie et qui était très beau et galant, est malheureusement décédé d'un cancer.
Les deux rumeurs que j'ai mentionnées ne sont que des rumeurs et ne doivent pas être prises au sérieux.
Ces questions et réponses proviennent des utilisateurs du site, elles ne représentent pas la position du site, s'il y a une infraction, veuillez contacter l'administrateur pour la supprimer.